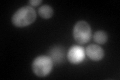
YLL009C
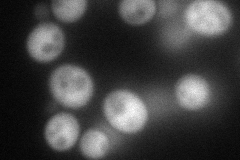
YLL009C
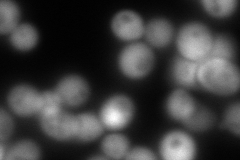
YLL009C
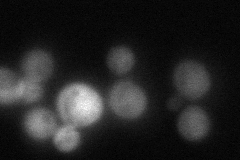
YLL009C
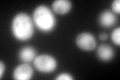
YLL009C
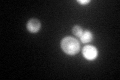
YLL009C

View description
Copper metallochaperone that transfers copper to Sco1p and Cox11p for eventual delivery to cytochrome c oxidase; contains twin cysteine-x9-cysteine motifs
Localization:
Intensity:
Fold change:
Significance:
-
C’ GFP library in SD
cytosol130.88 -
N' NOP1pr-GFP in SD
cytosol91.9925 -
N' TEF2pr-mCherry in SD
cytosol52.3673 -
N' NATIVEpr-GFP in SD
cytosol46.5089 -
N' TEF2pr-VC and Cyto-VN in SD

#N/A0 -
C’ GFP library in SD+DTT
cytosol184.471.4Yes -
C’ GFP library in SD+H2O2

cytosol135.831.03No -
C’ GFP library in Starvation Media
cytosol257.711.96Yes -
C’ GFP library on the background of Pup2-DaMP

cytosol -
C’ GFP library on the background of CCT mutant

cytosol108.4110.828248No
